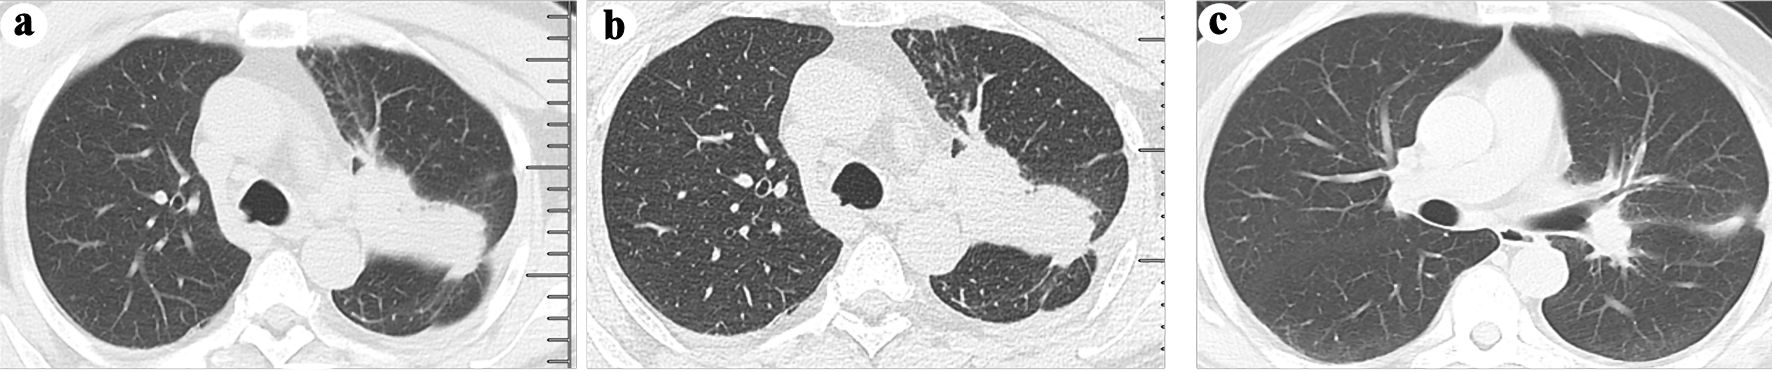

| World Journal of Oncology, ISSN 1920-4531 print, 1920-454X online, Open Access |
| Article copyright, the authors; Journal compilation copyright, World J Oncol and Elmer Press Inc |
| Journal website https://www.wjon.org |
Case Report
Volume 15, Number 4, August 2024, pages 731-735
Proximal Femoral Metastasis From Epidermal Growth Factor Receptor-Mutated Lung Adenocarcinoma Mimicking Osteosarcoma on Magnetic Resonance Imaging
Chang Jun Chena, c, d , Jun Feng Yina, c, Hao Xuan Zhanga, Qing Wei Maa, Xin Zhaob, Meng Chena, Da Yong Penga, d
aDepartment of Orthopedic Surgery, The First Affiliated Hospital of Shandong First Medical University and Shandong Provincial Qianfoshan Hospital, Shandong Key Laboratory of Rheumatic Disease and Translational Medicine, Jinan, China
bDepartment of Orthopedic Surgery, Shandong Provincial Hospital Affiliated to Shandong First Medical University, Jinan, China
cThese two authors contributed equally to this work.
dCorresponding Author: Chang Jun Chen, Department of Orthopedic Surgery, The First Affiliated Hospital of Shandong First Medical University and Shandong Provincial Qianfoshan Hospital, Shandong Key Laboratory of Rheumatic Disease and Translational Medicine, Jinan, China; Da Yong Peng, Department of Orthopedic Surgery, The First Affiliated Hospital of Shandong First Medical University and Shandong Provincial Qianfoshan Hospital, Shandong Key Laboratory of Rheumatic Disease and Translational Medicine, Jinan, China
Manuscript submitted April 29, 2024, accepted June 6, 2024, published online July 5, 2024
Short title: Uncommon Spread of Lung Cancer
doi: https://doi.org/10.14740/wjon1888
| Abstract | ▴Top |
The aggressive nature of lung cancer is frequently accompanied by a high incidence of bone metastasis; however, proximal femoral metastasis from lung cancer is comparatively uncommon when compared to other malignancies. In this report, we present the case of a 53-year-old Asian male who presented with pain in the left thigh and back. Magnetic resonance imaging revealed severe bone destruction with involvement of adjacent soft tissue mass at the left thigh, exhibiting imaging findings that mimic osteosarcoma. Subsequent bone biopsy confirmed the diagnosis of epidermal growth factor receptor (EGFR)-mutated lung adenocarcinoma with bone metastasis. The patient achieved survival following administration of osimertinib and underwent surgery for femoral metastases without palliative surgery for lung cancer. Therefore, proximal femoral metastasis from EGFR-mutated lung adenocarcinoma should be considered as a differential diagnosis in patients suspected to have osteosarcoma. The imaging findings of proximal femoral metastasis from EGFR-mutated lung adenocarcinoma were presented, and their therapeutic management was discussed.
Keywords: Proximal femoral metastasis; EGFR mutation; Lung adenocarcinoma; Osteosarcoma
| Introduction | ▴Top |
Lung cancer, especially lung adenocarcinomas, is a commonly diagnosed malignancy in the world and is associated with high frequencies of bone metastases [1, 2]. As metastasis becomes the leading cause of cancer-related deaths, emerging studies have been focusing on revealing the mechanism of metastasis to control this adverse process. Studies have found that manipulating immune cells, such as pro-metastatic macrophages and reprogrammed CD8+ T lymphocytes, can significantly inhibit lung metastases via their antitumor activity [3-6]. For example, Celus et al have found that macrophage caveolin-1 signaling is critical for metastasis, whose inhibition may drive lung metastatic growth via promoting angiogenesis [7]. The bone metastasis of lung cancer is commonly located in the spine, with a lesser extent in the ribs, pelvis and proximal femur [8]. Unlike the common site of osteosarcoma, such as distal femur, proximal tibia, and proximal humerus, proximal femur was an uncommon site of osteosarcoma [9]. Here, we describe an interesting case of epidermal growth factor receptor (EGFR) mutant lung adenocarcinoma with proximal femoral metastasis, whose imaging findings (severe cortical bone destruction and a large soft tissue mass) mimic osteosarcoma.
| Case Report | ▴Top |
Investigations
We admitted a 53-year-old smoking Asian male. He has a 1-month history of persistent swelling pain in his left thigh and back. The pain was more severe at night. His laboratory studies of arrival showed (normal reference ranges are given in parenthesis) white blood cell count of 8.38 × 109/L (3.5 - 9.5 × 109/L); neutrophil percentage 51.9% (40-75%); hemoglobin 152 g/L (130 - 175 g/L); albumin 40.5 g/L (40 - 55 g/L); calcium 2.35 mmol/L(2.09 - 2.54 mmol/L); carcinoembryonic antigen 137.61 ng/mL (0 - 5 ng/mL); carbohydrate antigen 125 167.5 U/mL (0 - 35 U/mL); carbohydrate antigen 19-9 10.94 U/mL (0 - 27 U/mL); ferritin 531.78 ng/mL (21.8 - 274.66 ng/mL); neuron specific enolase 26.63 ng/mL (0 - 16.3 ng/mL); and cytokeratin 19 fragment 3.53 ng/mL (0.1 - 3.3 ng/mL). The rest of the results of the laboratory studies were almost normal. On physical examination, a lump was found on his left lower extremity, which was tough and lacks mobility, causing pain when pressed.
Diagnosis and treatment
Then we arranged a magnetic resonance imaging (MRI) to examine the thigh, hip joint, and the spine. The results of thigh and hip joint revealed aggressive cortical destruction of left proximal femur, with an adjacent extraosseous soft tissue mass. MRI results also showed possible multiple bone metastases to the right proximal femur, bilateral ilium, bilateral ischium, bilateral pubis, and spine (Fig. 1a-d). Accidentally, the patient develops spontaneous fracture of left proximal femur, which could not enable a computed tomography (CT) scan due to unbearable pain. Therefore, an ultrasound-guided needle biopsy of the mass was conducted, and lung adenocarcinoma was diagnosed based on pathologic examination. In order to facilitate further examination and treatment, we applied external fixation to temporarily fix the displaced pathological fracture. Then, we conducted chest CT, with results showing a lesion at the left upper lobe (Fig. 2a, b), which is finally revealed as stage IV adenocarcinoma (Fig. 3a-c). Then the patient was transferred to the oncology department for further management, where mutational analysis of the tumor revealed an EGFR exon 19 deletions mutation, and the patient then received osimertinib, an EGFR-tyrosine kinase inhibitor (TKI).
![]() Click for large image | Figure 1. (a-c) MRI scans indicating potential multiple metastatic lesions in bilateral proximal femur, ilium, ischium, pubis, and spine. (b) T1-weighted sagittal spin-echo sequence of the thigh and hip joint displaying a hypointense lesion in the left proximal femur. (c, d) T2-weighted sagittal spin-echo sequence with fat-suppression demonstrating a hyperintense lesion involving intraosseous and extraosseous soft tissue in the left proximal femur. MRI: magnetic resonance imaging. |
![]() Click for large image | Figure 2. (a) A neoplasm in the left upper lobe was observed on a computed tomography (CT) scan. (b) The presence of a neoplasm in the left lung was confirmed through an enhanced CT scan. (c) A follow-up CT scan at 3 months after osimertinib administration revealed shrinkage of the neoplasm in the left upper lobe. |
![]() Click for large image | Figure 3. (a) H&E staining (original magnification, × 400) depicting tumor cell morphology. Immunohistochemical analysis revealed expressions of CK7 ((b) original magnification, × 400) and TTF1 ((c) original magnification, × 400), confirming the diagnosis of lung adenocarcinoma. H&E: hematoxylin and eosin; CK7: cytokeratin 7; TTF1: thyroid transcription factor 1. |
Follow-up and outcomes
At the 3-month follow-up, he exhibited a favorable response to osimertinib without any further deterioration of his condition (Fig. 2c). Additionally, he underwent left proximal femoral replacement at a local hospital. At the 6-month follow-up, he achieved disease stability and regained the ability to ambulate freely.
| Discussion | ▴Top |
Bone metastasis frequently occurs in lung cancer, including lung adenocarcinomas [1]. According to a retrospective study, the mean age of patients with lung cancer and bone metastases is 61.5 years, and most of the patients were presented between 50 and 59 or 60 and 69 years old [10]. Among the oncogenic mutations, EGFR mutations are the most commonly identified mutation in non-small cell lung cancer, including squamous cell carcinoma, lung adenocarcinoma, and large cell carcinoma; Of which, EGFR exon 21 L858R mutations are the most common mutation in EGFR followed by EGFR exon 19 deletions and EGFR exon 20 insertion mutations (exon20ins) [11]. The presence of EGFR mutation in lung cancer can induce the upregulation of the EGFR signaling pathway, consequently resulting in an increase in vascular endothelial growth factor (VEGF) expression to promote angiogenesis and facilitate tumor invasion and metastasis [12, 13]. Additionally, exosomes derived from lung cancer cells have been shown to activate the EGFR pathway, resulting in increased receptor activator of nuclear factor kappa B ligand (RANKL) expression and subsequent induction of osteoclastogenesis, ultimately facilitating osteolytic bone metastasis [14, 15]. Therefore, numerous mechanisms may underlie the promotion of rare bone metastasis in EGFR-mutated lung adenocarcinoma.
And EGFR-mutant lung adenocarcinoma shared a similar bone metastatic features with overall lung cancer. According to a retrospective study, spine remains the most common site of bone metastasis for those patients, followed by ribs, pelvis, scapula, femur, humerus, and skull, whose finding was mostly in consistent with previous reports [8, 16]. Among them, femur metastasis only occurs in approximately 7.7% patients of lung adenocarcinomas with bone metastasis [16]. Moreover, studies have found that the prognosis was poor in patients with metastasis to the femur [8]. For patients with EGFR exon 19 deletions, osteolytic bone metastasis is commonly observed, and these patients can benefit from the administration of bisphosphonate at least six times for a duration exceeding 1 year to effectively reduce the occurrence of skeletal-related events [16]. In our case, the patient develops spontaneous fracture of his left femur during the hospitalization, which highlights the importance of protecting affected limb after admission to hospital.
Osteosarcoma is the most common primary malignant bone tumor, which primarily attacks younger patients, especially patients with an age of 10 to 30 years. The tumors usually involve extremities, including distal femur, proximal tibia, and proximal humerus and show high frequencies of lung metastases [9, 17, 18]. However, the proximal femur is a rare site of osteosarcoma, where they may have some unusual manifestations and pose diagnostic and therapeutic mistakes [9]. According to a retrospective study, no patients with proximal femoral osteosarcoma reported typical symptoms of pain with a soft tissue swelling; on imaging, 92% lesions were osteolytic and had immature osteoid matrix, 58% lesions involved soft tissue, and 8% lesions had a periosteal reaction [9]. Imageology examination is important for the evaluation of osteosarcoma. Of which, radiography of osteosarcoma can vary from osteolytic to osteoblastic depending on the amount of mineralized matrix. CT can be used to early detect metastases in the lung, while MRI can be used to evaluate the intraosseous and extraosseous tumor extent [19]. In our case, his initial MRI showed osteolytic lesions with extensive intraosseous and extraosseous involving, whose manifestations favored the diagnosis of atypical osteosarcoma. However, the pathological diagnosis of the mass after needle biopsy was lung adenocarcinomas, which is far from our initial diagnosis. Thus, we highlighted the importance of making final diagnosis based on not only imaging tests but also histopathological studies.
Most of the lung cancers are detected at an advanced stage. As for the management of cancer, studies have recommended to conduct comprehensive treatment for disease control, such as pain management, immunotherapy and chemotherapy and surgery [1]. Among them, antiresorptive drug, such as zoledronic acid and denosumab, was recommended to initiate as soon as possible when bone metastases appear or when it became symptomatic [20]. Palliative surgery, such as performing lobectomy plus lymph node resection, of the primary site of stage IV non-small cell lung cancer, was also recommended for patients that can tolerate the surgery [21, 22]. For patients with advanced-stage EGFR mutated lung adenocarcinoma, TKIs, such as osimertinib, are the primary therapeutic option. Studies have shown that TKI with lung cancer salvage surgery may prolong the overall survival of these patients by removing TKI-resistant subclones [23, 24]. However, for proximal femoral metastasis derived from lung adenocarcinoma, the data of clinical management and surgical treatment of metastasis are scarce. A retrospective study included 148 consecutive patients of femoral metastases demonstrated that internal fixation, which is a less invasive and time-saving procedure, is beneficial for patients with short-term expected survival, and that endoprosthetic replacement may offer favorable long-term results [25]. In our case, the patient underwent immunotherapy and received external fixation for a spontaneous fracture of his left femur. Following improvement in his condition, he subsequently underwent surgical intervention for femoral metastases at a local hospital; however, no surgical procedure was performed for lung cancer. After a follow-up period of 6 months, the patient showed positive response to TKIs, and there was no further deterioration of his condition. Therefore, surgery for femoral metastases would be beneficial if the patient can tolerate the surgery; however, studies with a high level of evidence are needed to verify our recommendations.
Acknowledgments
None to declare.
Financial Disclosure
This work was supported by the Natural Science Foundation of Shandong Province (grant number: ZR2023QH517, ZR2022QH252); Clinical Medical Science and Technology Innovation Program of Jinan Science and Technology Bureau (grant number: 202328059); Foundation of Research Hospital Association of Shandong Province (grant number: 2022016); Foundation of Scientific Research Incubation of Shandong First Medical University and Shandong Academy of Medical Sciences (grant number: 202201-086).
Conflict of Interest
The authors declared no conflict of interest.
Informed Consent
Written informed consent was obtained from the patient.
Author Contributions
CJC and JFY participated in the drafting, writing, and revising of the manuscript. HXZ, QWM, XZ, MC and DYP participated in the data selection and analysis. CJC and DYP contributed to the study concept and acquired and analyzed the data. All authors contributed to the drafting of the manuscript and figure preparation.
Data Availability
The data sets used and/or analyzed during the current study are available from the corresponding author upon reasonable request.
| References | ▴Top |
- Chen CJ, Yan TB, Liu YD, Wang Y, Zhao X, Qi YB, Wu YG, et al. Multiple myeloma rather than metastatic lung cancer: an unexpected cause of spinal cord compression. World J Oncol. 2023;14(5):438-442.
doi pubmed pmc - Chen CJ, Zhao X, Zhao JW, Ma XJ, Xu WH, Qi YB, Li JK, et al. Osteoblastic bone reaction developing during treatment with sintilimab and bevacizumab in a patient with KRAS(G12V)-mutant lung adenocarcinoma. World J Oncol. 2023;14(6):580-583.
doi pubmed pmc - Ding C, Shrestha R, Zhu X, Geller AE, Wu S, Woeste MR, Li W, et al. Inducing trained immunity in pro-metastatic macrophages to control tumor metastasis. Nat Immunol. 2023;24(2):239-254.
doi pubmed pmc - Skurikhin EG, Pershina O, Ermakova N, Pakhomova A, Widera D, Zhukova M, Pan E, et al. Reprogrammed CD8(+) T-lymphocytes isolated from bone marrow have anticancer potential in lung cancer. Biomedicines. 2022;10(6):1450.
doi pubmed pmc - Chen C, Zhao X, Luo Y, Li B, Li Q, Zhao C, Huang Y, et al. Imbalanced T-cell subsets may facilitate the occurrence of osteonecrosis of the femoral head. J Inflamm Res. 2022;15:4159-4169.
doi pubmed pmc - Chen C, Fu L, Luo Y, Zeng W, Qi X, Wei Y, Chen L, et al. Engineered exosome-functionalized extracellular matrix-mimicking hydrogel for promoting bone repair in glucocorticoid-induced osteonecrosis of the femoral head. ACS Appl Mater Interfaces. 2023;15(24):28891-28906.
doi pubmed - Celus W, Di Conza G, Oliveira AI, Ehling M, Costa BM, Wenes M, Mazzone M. Loss of Caveolin-1 in metastasis-associated macrophages drives lung metastatic growth through increased angiogenesis. Cell Rep. 2017;21(10):2842-2854.
doi pubmed pmc - Sugiura H, Yamada K, Sugiura T, Hida T, Mitsudomi T. Predictors of survival in patients with bone metastasis of lung cancer. Clin Orthop Relat Res. 2008;466(3):729-736.
doi pubmed pmc - Dahan M, Anract P, Babinet A, Larousserie F, Biau D. Proximal femoral osteosarcoma: Diagnostic challenges translate into delayed and inappropriate management. Orthop Traumatol Surg Res. 2017;103(7):1011-1015.
doi pubmed - Utzschneider S, Wicherek E, Weber P, Schmidt G, Jansson V, Durr HR. Surgical treatment of bone metastases in patients with lung cancer. Int Orthop. 2011;35(5):731-736.
doi pubmed pmc - Brazel D, Kroening G, Nagasaka M. Non-small cell lung cancer with EGFR or HER2 Exon 20 insertion mutations: diagnosis and treatment options. BioDrugs. 2022;36(6):717-729.
doi pubmed pmc - van der Pluijm G, Sijmons B, Vloedgraven H, Deckers M, Papapoulos S, Lowik C. Monitoring metastatic behavior of human tumor cells in mice with species-specific polymerase chain reaction: elevated expression of angiogenesis and bone resorption stimulators by breast cancer in bone metastases. J Bone Miner Res. 2001;16(6):1077-1091.
doi pubmed - Le X, Nilsson M, Goldman J, Reck M, Nakagawa K, Kato T, Ares LP, et al. Dual EGFR-VEGF pathway inhibition: a promising strategy for patients with EGFR-mutant NSCLC. J Thorac Oncol. 2021;16(2):205-215.
doi pubmed - Taverna S, Pucci M, Giallombardo M, Di Bella MA, Santarpia M, Reclusa P, Gil-Bazo I, et al. Amphiregulin contained in NSCLC-exosomes induces osteoclast differentiation through the activation of EGFR pathway. Sci Rep. 2017;7(1):3170.
doi pubmed pmc - Chen C, Wang B, Zhao X, Luo Y, Fu L, Qi X, Ying Z, et al. Lithium promotes osteogenesis via Rab11a-facilitated exosomal Wnt10a secretion and beta-catenin signaling activation. ACS Appl Mater Interfaces. 2024;16(24):30793-30809.
doi pubmed - Gu L, Gong T, Ma Q, Zhong D. Retrospective study of EGFR-mutant lung adenocarcinoma with bone metastatic clinical features. Cancer Rep (Hoboken). 2023;6(1):e1628.
doi pubmed pmc - Zhao X, Fang Y, Wang X, Yang Z, Li D, Tian M, Kang P. Knockdown of Ski decreases osteosarcoma cell proliferation and migration by suppressing the PI3K/Akt signaling pathway. Int J Oncol. 2020;56(1):206-218.
doi pubmed pmc - Bacci G, Rocca M, Salone M, Balladelli A, Ferrari S, Palmerini E, Forni C, et al. High grade osteosarcoma of the extremities with lung metastases at presentation: treatment with neoadjuvant chemotherapy and simultaneous resection of primary and metastatic lesions. J Surg Oncol. 2008;98(6):415-420.
doi pubmed - Zwaga T, Bovee JV, Kroon HM. Osteosarcoma of the femur with skip, lymph node, and lung metastases. Radiographics. 2008;28(1):277-283.
doi pubmed - Confavreux CB, Pialat JB, Belliere A, Brevet M, Decroisette C, Tescaru A, Wegrzyn J, et al. Bone metastases from lung cancer: A paradigm for multidisciplinary onco-rheumatology management. Joint Bone Spine. 2019;86(2):185-194.
doi pubmed - Ren J, Ren J, Wang K, Tan Q. The consideration of surgery on primary lesion of advanced non-small cell lung cancer. BMC Pulm Med. 2023;23(1):118.
doi pubmed pmc - Yokoi K, Taniguchi T, Usami N, Kawaguchi K, Fukui T, Ishiguro F. Surgical management of locally advanced lung cancer. Gen Thorac Cardiovasc Surg. 2014;62(9):522-530.
doi pubmed - Chen YY, Lin KH, Kuo YS, Tsai YM, Huang HK, Huang TW. Therapeutic impact of epidermal growth factor receptor tyrosine kinase inhibitor with various treatment combinations for advanced lung adenocarcinoma. World J Surg Oncol. 2023;21(1):326.
doi pubmed pmc - Lin MW, Yu SL, Hsu YC, Chen YM, Lee YH, Hsiao YJ, Lin JW, et al. Salvage surgery for advanced lung adenocarcinoma after epidermal growth factor receptor tyrosine kinase inhibitor treatment. Ann Thorac Surg. 2023;116(1):111-119.
doi pubmed - Tanaka A, Katagiri H, Murata H, Wasa J, Miyagi M, Honda Y, Takahashi M. Surgery for femoral metastases. Bone Joint J. 2020;102-B(3):285-292.
doi pubmed
This article is distributed under the terms of the Creative Commons Attribution Non-Commercial 4.0 International License, which permits unrestricted non-commercial use, distribution, and reproduction in any medium, provided the original work is properly cited.
World Journal of Oncology is published by Elmer Press Inc.